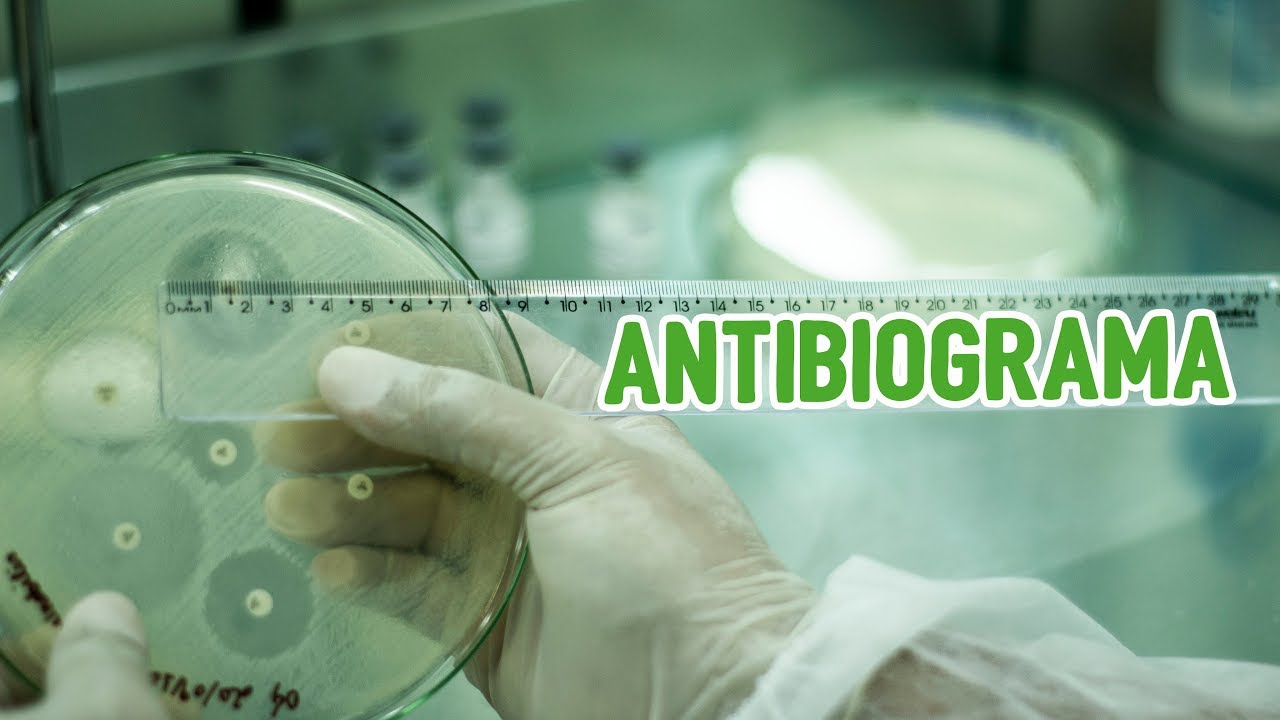
Como fazer e interpretar o Antibiograma?

a patologia e saúde apresenta eu estou tecnologia é isso tecnologia é o estudo dos tecidos normais ou patológicos isso é suas células e os elementos da matriz extracelular através de métodos de preparados histológicos permanentes para estudos ao microscópio óptico incluindo técnicas se tô clínicas histoquímicas imuno-histoquímicas e oi oi este estudo podem o diagnosticar em amostra de tecido humano animal ou vegetal qualquer que seja a doença conduzir pesquisas aulas de histopatologia botânica e zoologia excessivos são removidos durante a cirurgia seja ele organismo viu através de biópsia ou pouso nós tem fazendo necrópsia e os procedimentos utilizados
para exame microscópico inclui coleta do material fixação clivagem inclusão microtomia coloração montagem e observação ao microscópio na fase de fixação acontece a interrupção do metabolismo celular evita autólise das células e acontece a preservação de estruturas e componentes bioquímicos os fixadores são substâncias químicas que mantém a integridade do tecido após a morte e sem alterações da estrutura celular como o formol eo metacarpo na etapa da clivagem é realizada uma seleção macroscópica do tecido a fim de reduzir dimensões os fragmentos e facilitar a penetração dos fixadores e difusão dos reagentes durante as etapas subsequentes após a clivagem
os fragmentos são colocados nos café e para realização da desidratação e e já na etapa da desidratação acontece a retirada da água no interior das células a fim de permitir a impregnação da peça com parafina para isso até ser submetida ao banho sucessivos em álcool de terror crescente a clarificação é realizada para remover completamente o álcool do interior dos tecidos a remoção do álcool é de extrema importância pois a parafina não se mistura homogénea mente com o álcool utiliza-se nessa etapa o xilol conforme o sol penetra no tecido em substituição ao álcool material se torna
mais claro e transparente hoje mas tava da impregnação utiliza-se a estufa 60 graus celsius os fragmentos eles devem ser transportados de uma parafina a outra em um intervalo de tempo pré-determinados para remover todos tirol dos tecidos na fase da inclusão deve-se aquecer a parafina já que se apresenta no estado sólido e somente em temperaturas entre 60 e 6 graus celsius a 60 graus celsius torna-se líquido em seguida preenche o molde com parafina letra com auxílio de uma pinça e selecionar os fragmentos da morte colocando no interior do norte colocar a base no cassete sobre o
molde de maneira que a parafina entre em contato com café utilizar o papel para escrever identificar o bloco levar o molde com material incluído para a placa resfriada e fofinho e retirar o bloco do mot já pode começar a suar a e na etapa da microfonia os tecidos devem ser seccionados e fatias bem finas e uniformes a espessura ideal varia de acordo com o objetivo do estudo recomenda-se a espessura de 4 a 6 micrômetros na rotina dos laboratórios os tecidos são cortados em um instrumento chamado metrópole e em seguida os tecidos são colocados em uma
lâmina na fase da coloração dos tecidos é utilizado corantes que é fundamental para visualizar os tecidos ao microscópio e tem a finalidade de dar contraste aos componentes dos tecidos tornando visíveis e destacados uns dos outros os corantes aplicados para cortar tecidos que foram previamente fixados são chamados de corantes não vitais com uma hematoxilina-eosina toxina e entre outros o finn realiza-se acaba da montagem e cons a imagem da lâmina sobre o copo com base no do canadá a lâmina impede que haja hidratação do corte pela umidade ambiente após a montagem levam-se as lâminas a estufa para
secagem do bálsamo do canadá após todas as etapas a lâmina está pronta para ser examinado ao microscópio e e se você gostou do nosso vídeo signos no youtube e compartilhe o nosso vídeo e